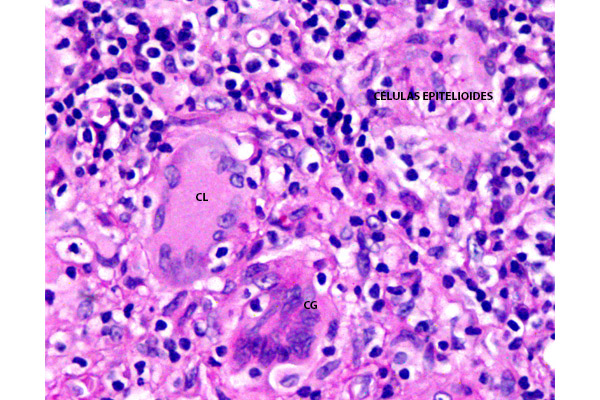
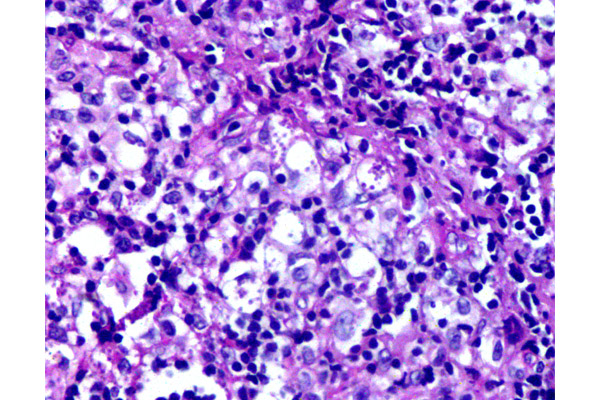

La leishmaniasis cutánea en el párpado comparte las características histológicas generales de la forma cutánea, pero su localización periocular (cercana a estructuras sensibles) la hace particularmente importante. La histopatología de la leishmaniasis cutánea varía según la fase evolutiva de la lesión y la respuesta inmunológica del paciente.
Se aprecian cambios cónsonos con una dermatitis granulomatosa crónica con ulceración.

Este infiltrado es típicamente granulomatoso e incluye, macrófagos, células gigantes multinucleadas de tipo Langhans y de tipo cuerpo extraño, formadas por la fusión de macrófagos, así como linfocitos y células plasmáticas, especialmente en la periferia de los granulomas.

La característica más notable es un infiltrado inflamatorio denso y difuso que ocupa la dermis.

El infiltrado inflamatorio es intenso, a menudo respetando un «espacio» debajo de la epidermis (la zona de Grenz). Sin embargo, como en este caso puede estar ausente por la extensa ulceración.

Destaca la presencia de células gigantes multinucleadas de tipo Langhans y de tipo cuerpo extraño.

En las fases agudas, la lesión es rica en parásitos y en el infiltrado predominan los macrófagos espumosos cargados de parásitos y una respuesta celular mixta de tipo histiocitaria.

El diagnóstico definitivo requiere la identificación de la forma intracelular del parásito: el amastigote de Leishmania (o corpúsculo de Leishman-Donovan), observados con coloración de PAS, en esta imagen, en las áreas señaladas con elipses.
Abundantes células gigantes de tipo Langhans (CL), de tipo cuerpo extraño (CG) y células epitelioides, en el espesor de los granulomas.

Los microabscesos pueden alcanzar las capas más profundas del párpado, disecando las fibras musculares estriadas del orbicular de los párpados (FM).
A mayor aumento se aprecian los macrófagos espumosos cargados de parásitos, teñidos de magenta con coloración de PAS, Estos amastigotes son cuerpos redondos u ovalados, pequeños, de 2 – 5 µm de diámetro, de ubicación intracelular exclusiva.

Con la tinción de Giemsa se tiñen los amastigotes. El estudio histológico de estas lesiones es necesario para descartar malignidad u otras causas granulomatosas (tuberculosis, micobacterias atípicas, sarcoidosis, etc.). Las coloraciones son necesarias para identificar microorganismos.



